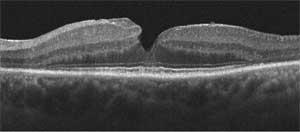
ARVO/ISIE explored advanced uses of OCT imaging of the eyes.

IMAGING FOR OPHTHALMOLOGY: OCT explorations pervade ARVO/ISIE annual meeting
At the annual meeting of the Association for Research in Vision and Ophthalmology/International Society for Imaging in the Eye (ARVO/ISIE; www.arvo.org), 20 of the 24 presentations mentioned optical coherence tomography (OCT) in their titles. So did three posters–and nearly all of the other presentations referred to OCT.
The event, held May 1 and 2 in Ft. Lauderdale, FL, attracted more than 140 of the world’s leading experts in ophthalmic imaging. The meeting’s goal is to present clinical and basic science advances in glaucoma, retina, cornea, anterior segment, orbit, and neuro-imaging in ophthalmology.
Ophthalmic OCT pioneer James Fujimoto presented “Ultrahigh Speed Imaging with Spectral and Swept Source Fourier Domain OCT,” in which he demonstrated how using spectral and swept-source/Fourier domain OCT at 800 and 1050 nm wavelengths enabled him to image ten times faster than with current technology and 100 times more quickly than with previous technology. This process allowed him to reduce eye-motion artifacts and perform volumetric 3D-OCT imaging with very high pixel density resolution.
Courses were presented on imaging technology, Glaucoma, retinal imaging, adaptive optics, novel imaging applications and image processing.
Glaucoma was clearly of major interest to the assembled researchers: imaging the optic-nerve head, as well as the thickness of the ganglion-cell complex, and the retinal-nerve fiber layer were recurring themes. Much of the research focused on earlier detection, improved treatment monitoring, and ultimately better understanding of the disease.
The adaptive-optics course proposed implementing the increasingly popular technology into current imaging modalities. Three out of the four presentations used adaptive-optics-enabled technologies in conjunction with standard imaging techniques to achieve some interesting results. Course chair Joseph Carroll’s team from the Medical College of Wisconsin demonstrated how the technology can be used in atypical cases to identify irregularities in retinal microstructures that remain invisible to commercially available clinical imaging systems.
In the Novel Imaging Applications course researchers from the Rudolph Foundation Clinic (Vienna, Austria) and Carl Zeiss Meditec (Dublin, CA) demonstrated that intrasurgical SD-OCT evaluation is feasible and may offer surgeons additional information in cases where preoperative OCT is not an option.
About the Author
Mark Zacharria
Mktg/Comms
Mark Zacharria is cofounder and senior consultant of Elucido Partners (Paris, France).